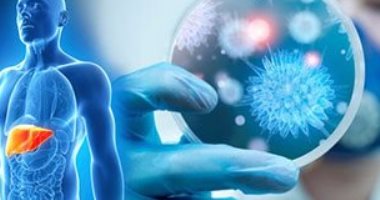
أفريقيا تستفيد من خبر مصر فى القضاء على فيروس سى.. التفاصيل

أخبار مصر
أفريقيا تستفيد من خبر مصر فى القضاء على فيروس سى.. التفاصيل
أثناء المؤتمر والمعرض الطبى الأول فى أفريقيا قال الدكتور أحمد أوما القائم بأعمال مدير الوكالة الأفريقية لمكافحة الأمراض والأوبئة، “نحن نستفيد من خبرة مصر في التعامل مع فيروس سي، ونحن مستعدين للعمل في هذا الأمر”، وهو الأمر الذى يشير بوضوح إلى حجم النجاح الذى حققته مصر فى هذا المجال.
فى تقرير سابق للهيئة العامة للاستعلامات تم استعراض الإنجازات التى تحققت فى قطاع الصحة خلال السنوات الاخيرة، حيث أشار الى حملة القضاء على فيروس سى، وذكر التقرير أن رئيس الجمهورية أطلق الحملة من خلال منظومة مصرية تحقق لمصر القضاء على الفيروس وآثاره السلبية على حياة الإنسان وإنتاجيته وحقه في الحياة الكريمة.
وتظهر أهمية برنامج مكافحة وعلاج فيروس سى، من خلال حجم الوضع الوبائى للفيروسات الكبدية B و C فى مصر ، كما يلى:
ـ عام 2015 (الفئة العمرية من 1–59 عام) بلغ معدل الإصابة بالالتهاب الكبدي الفيروسي بي 1% ومعدل الإصابة بالالتهاب الكبدي الفيروسي سي 4.4%، وكلما زاد السن ترتفع معدلات انتشار الفيروس.
ففي عام 2008 في الفئة العمرية من 55 إلى 59 عام بلغت نسبة الانتشار 27.4% وفي العام 2015 بلغت النسبة 22.3%، ويقدر عدد المصابين بمرض الالتهاب الكبدي الفيروسي B حوالي 800,000 شخص، فيما يقدر عدد المصابين بمرض الالتهاب الكبدي الفيروسى C حوالى 3.6 مليون شخص.
5 سنوات حولت مصر فيها وضعها من أكبر دولة في العالم يعاني سكانها من فيروس سي إلى الأولى في مكافحته، فبدأت رحلة الصعود إلى القمة من خلال عدة مبادرات أطلقتها عدة جهات أهلية وحكومية منها صندوق تحيا مصر ووزارة الصحة بتكليفات من الرئيس عبد الفتاح السيسي .
4.5 مليون مصاب بالفيروس تعايشوا معه منذ سنوات طويلة وعانوا من الأضرار التي ترتبت على عدم علاجه حتى بدأت المبادرة الحكومية بالقضاء على فيروس سي في عام 2014، وعالجت خلال 4 سنوات 3 مليون مصري .